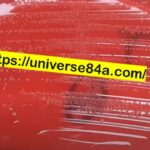
Enterococcus faecalis- Introduction, Morphology, Pathogenicity, Lab Diagnosis, Treatment, Prevention, and Keynotes_

Tag: Enterococcus
Vancomycin-Resistant Enterococcus (VRE)-Introduction, Detection Methods, and Keynotes
 Introduction of Vancomycin-Resistant Enterococcus (VRE) Vancomycin-Resistant Enterococcus (VRE) refers to strains...
Introduction of Vancomycin-Resistant Enterococcus (VRE) Vancomycin-Resistant Enterococcus (VRE) refers to strains...
Enterococcus faecalis: Introduction, Morphology, Pathogenicity, Lab Diagnosis, Treatment, Prevention, and Keynotes
Introduction Enterococcus faecalis, formerly known as Streptococcus faecalis, is a...
Introduction Enterococcus faecalis, formerly known as Streptococcus faecalis, is a...
Bile Esculin Test: Introduction,Principle, Procedure, Result Interpretation and Limitations
 Introduction of Bile Esculin test Bile esculin test is widely...
Introduction of Bile Esculin test Bile esculin test is widely...
